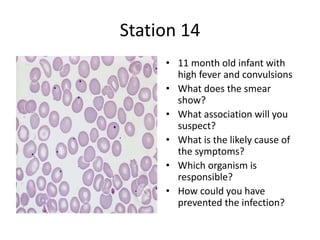
Station 14
• 11 month old infant with
high fever and convulsions
• What does the smear
show?
• What association will you
suspect?
• What is the likely cause of
the symptoms?
• Which organism is
responsible?
• How could you have
prevented the infection?

The document contains summaries of 20 OSCE pediatric stations including questions on Down syndrome with esophageal atresia, typhoid vaccination recommendations, hemoglobin disorders, muscular dystrophies, transverse myelitis, Ehlers Danlos syndrome, pulmonary sequestration, Reiter's syndrome, enterobiasis, cleidocranial dysplasia, Wilson's disease, spinal cord injuries, Meckel's scan, congenital hypothyroidism, hemophilia A, neurocysticercosis and their diagnoses and management. The stations cover ethics, clinical examination, choice of investigations, interpretations of tests and forming differential diagnoses.